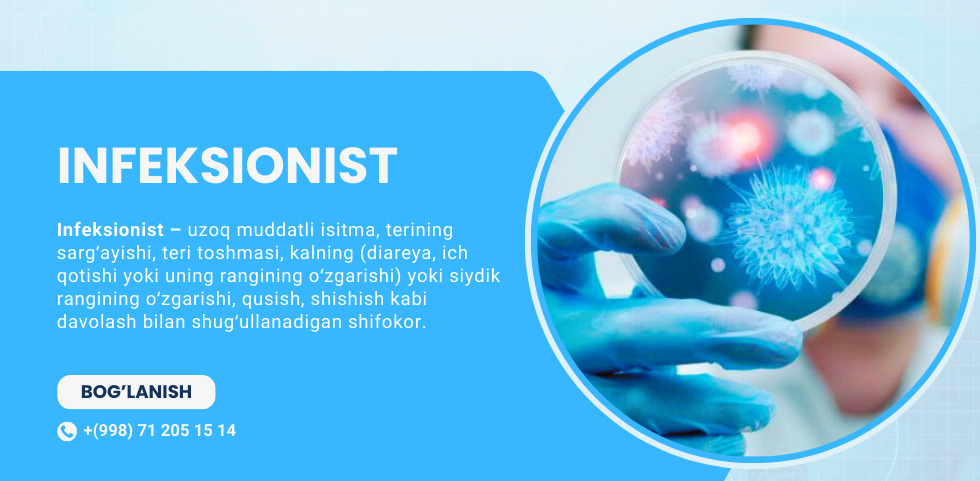
single

Infeksionist shifokor
Infeksionist – bu turli xil infeksion kasalliklarni tashxislash, davolash va oldini olish bilan shug‘ullanadigan tibbiyot mutaxassisi. Infeksionistlar bakterial, virusli, zamburug‘li va parazitar infeksiyalarni aniqlash va davolashda ixtisoslashgan. Milliy tibbiyot markazi infeksionistlari zamonaviy diagnostika va davolash usullaridan foydalangan holda, har bir bemorga individual yondashuvni ta’minlaydilar.
Infeksionistlar organizmda paydo bo‘ladigan infeksiyalarni aniqlash, ularning oldini olish va davolashda muhim rol o‘ynaydi. Milliy tibbiyot markazida infeksionistlar infeksion kasalliklarning oldini olish, davolash va asoratlarning oldini olish uchun keng qamrovli xizmatlar ko‘rsatadilar. Ular har bir bemor uchun xavfsiz va samarali davolash rejalarini ishlab chiqishga intiladilar.
Infeksion Kasalliklarning Belgilari
Infeksion kasalliklar organizmda turli xil simptomlar bilan namoyon bo‘lishi mumkin. Milliy tibbiyot markazi infeksionistlari ushbu simptomlarga e’tibor qaratib, kasalliklarni aniqlash va davolashda individual yondashuvni qo‘llaydi:
- Yuqori tana harorati: Ko‘plab infeksion kasalliklar tana haroratining ko‘tarilishi bilan kechadi, bu yallig‘lanish jarayonidan darak beradi.
- Bosh og‘rig‘i va charchoq: Infeksiyalar organizmda umumiy holsizlik, bosh og‘rig‘i va charchoq keltirib chiqarishi mumkin.
- Ishtahaning yo‘qolishi: Infeksiyalar ishtahaning yo‘qolishi yoki sezilarli darajada kamayishi bilan kechishi mumkin.
- Qorin og‘riqlari va ich ketishi: Ba’zi infeksiyalar qorin og‘rig‘i va ich ketishi bilan kechib, oshqozon-ichak yo‘llarining zararlanganligini ko‘rsatadi.
- Teridagi o‘zgarishlar: Infeksion kasalliklarda terida toshmalar, qizarish yoki boshqa o‘zgarishlar paydo bo‘lishi mumkin.
Infeksionist Bilan Maslahat
Infeksionist bilan maslahat infeksion kasalliklarni aniqlash va davolashda muhim bosqichdir. Milliy tibbiyot markazi infeksionistlari bemorga individual yondashuvni ta’minlab, davolash rejasini tuzadi:
- Shikoyatlarni yig‘ish: Bemorning asosiy shikoyatlari va infeksion kasalliklar bilan bog‘liq simptomlar o‘rganiladi.
- Tibbiy tarixni o‘rganish: Bemorning avvalgi kasalliklari, infeksiyalar va davolanish tarixi tekshiriladi.
- Jismoniy tekshiruv: Bemorning umumiy holati, tana harorati va infeksion kasalliklarning boshqa belgilarini baholash uchun maxsus tekshiruvlar o‘tkaziladi.
- Laborator tahlillar: Qon, siydik, balg‘am va boshqa biologik materiallarni tahlil qilish orqali infeksiyaning sabablarini aniqlash.
- Davolash rejasi: Tekshiruv natijalariga asoslanib, individual davolash rejasi ishlab chiqiladi va bemorga tavsiyalar beriladi.
Infeksionistlarda Diagnostika Usullari
Infeksion kasalliklarni aniqlash uchun zamonaviy diagnostika usullari qo‘llaniladi. Milliy tibbiyot markazi infeksionistlari quyidagi diagnostika usullari orqali kasalliklarni aniq tashxislashni ta’minlaydilar:
- Bakteriologik tahlillar: Qon, balg‘am yoki boshqa materiallardan olingan namunalar yordamida bakteriyalarni aniqlash va ularning turlarini aniqlash.
- Virusologik tahlillar: Viruslarni aniqlash uchun maxsus laborator tekshiruvlar o‘tkaziladi, bu infeksiyaning turini aniqlashga yordam beradi.
- Serologik tahlillar: Qon zardobi yordamida infeksiyaga qarshi antitanalarni aniqlash uchun qo‘llaniladi.
- Polimeraza zanjir reaksiyasi (PZR): Genetik materiallarni ko‘paytirish orqali infeksiyani aniqlash va uning turini tasdiqlash uchun foydalaniladi.
- Rentgen va ultratovush tekshiruvi: Tananing ichki a'zolaridagi o‘zgarishlarni aniqlash va infeksiyaning tarqalishini baholash uchun qo‘llaniladi.
Infeksionist Qanday Kasalliklarni Davolaydi?
Milliy tibbiyot markazi infeksionistlari turli xil infeksion kasalliklarni davolashda yuqori malakaga ega. Ular quyidagi kasalliklarni aniqlash va davolashda individual yondashuvni qo‘llaydilar:
- Bakterial infeksiyalar: Pneumoniya, streptokokk infeksiyalari, stafilokokk infeksiyalari kabi bakterial infeksiyalarni davolash.
- Virusli infeksiyalar: Gripp, gepatit, COVID-19, herpes va boshqa virusli infeksiyalarni davolash.
- Zamburug‘li infeksiyalar: Kandidoz, aspergilloz va boshqa zamburug‘li infeksiyalarni aniqlash va davolash.
- Parazitar infeksiyalar: Malariya, giardiaz va boshqa parazitar infeksiyalarni aniqlash va davolash.
- Immun tizimi kasalliklari: Otoimmun kasalliklar va infeksion jarayonlar bilan bog‘liq immun tizimi buzilishlarini davolash.
Bog‘lanish
Agar sizga infeksion kasalliklar bo‘yicha maslahat kerak bo‘lsa yoki qo‘shimcha ma’lumot olmoqchi bo‘lsangiz, quyidagi kontaktlar orqali bog‘lanishingiz mumkin:
Telefon raqami: +998 71 205 15 14 ☎️
Ish vaqti: Dushanba – Juma: 8:00 – 17:00, Shanba: 8:00 – 16:00 ⏰
Sizni Milliy tibbiyot markazimizda kutamiz va sizga yordam berishdan mamnun bo‘lamiz!
Xizmatlar narxi
- Infeksionist ko'rigi81000 so'm
Bizning Shifokorlar

Shavkatbekov Xurshidbek...
NeyroxirurgBizning shifokorlarmizni tez tanlashda imkoni mavjud va bizlarning shifokorlar oliy toifali.
Batafsil
Axmedova Gulchehra Po'l...
OtoloringologBizning shifokorlarmizni tez tanlashda imkoni mavjud va bizlarning shifokorlar oliy toifali.
Batafsil
Ibragimov Ulug'bek Darx...
kardiologBizning shifokorlarmizni tez tanlashda imkoni mavjud va bizlarning shifokorlar oliy toifali.
Batafsil
Roziqulov Nadir Madjido...
nevropatologBizning shifokorlarmizni tez tanlashda imkoni mavjud va bizlarning shifokorlar oliy toifali.
Batafsil
